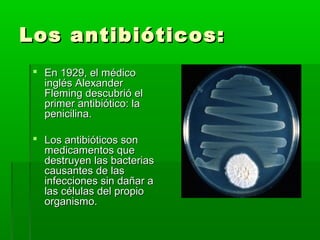
Los antibióticos:Los antibióticos:
 En 1929, el médicoEn 1929, el médico
inglés Alexanderinglés Alexander
Fleming descubrió elFleming descubrió el
primer antibiótico: laprimer antibiótico: la
penicilina.penicilina.
 Los antibióticos sonLos antibióticos son
medicamentos quemedicamentos que
destruyen las bacteriasdestruyen las bacterias
causantes de lascausantes de las
infecciones sin dañar ainfecciones sin dañar a
las células del propiolas células del propio
organismo.organismo.

El documento describe la salud y la enfermedad. Define la salud como un estado de completo bienestar físico, mental y social, no solo la ausencia de enfermedad. Explica que la enfermedad es una alteración en el funcionamiento del organismo. Describe varios tipos de microorganismos como bacterias, virus y hongos que pueden causar enfermedades infecciosas. También menciona enfermedades no infecciosas relacionadas con factores como la alimentación y el estilo de vida.